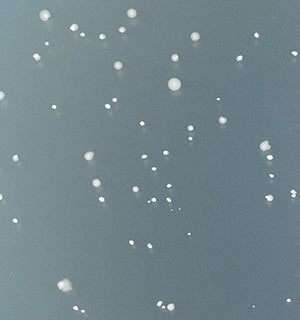

As we look forward, we believe we have a responsibility to reach for a more sustainable future.
MAKE products are formulated using botanical and botanically-derived ingredients and tested synthetic ingredients. In an effort to consider the environmental impact of ingredient sourcing and the safety and efficacy of our products, where possible, we utilize a biotech approach to formulation that we call Lab Engineered Natural Ingredients or “L.E.N.I”.